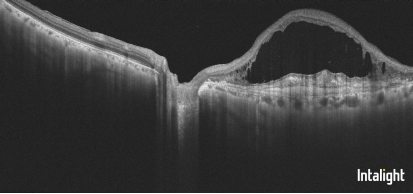

近日,西安市第九医院眼科接诊了一位患者原叔叔,他左眼视力下降伴视物变形多年,成静主任团队为原叔叔进行详细的眼底检查后诊断为“左眼新生血管性年龄相关性黄斑变性”,左眼视力仅有眼前指数,依据患者的病情,成静主任团队为原叔叔制定了左眼玻璃体腔注射法瑞西单抗的方案。

图为成静主任为患者进行眼科检查


图为董乐主治医师为患者进行玻璃体腔注药术
新生血管性年龄相关性黄斑变性,也被称为湿性年龄相关性黄斑变性(wAMD),是一种慢性进行性眼病。此病常见于50岁以上人群,通常随着年龄增长而发生,是一种常见于老年人群中的眼底疾病,也是目前全球眼科界公认的能引起中心视力丧失、较难治疗的眼病之一。顾名思义,年龄相关性黄斑变性与年龄密切相关,且病变累及黄斑区。由于黄斑区位于视网膜中央,是光线进入眼球之后被人眼的屈光系统如角膜、晶状体等精确聚焦之处。此处视锥细胞密集、神经元丰富、结构复杂,黄斑区视功能优劣与否与我们的视力、色觉密切相关。而年龄相关性黄斑变性恰恰损害发生于黄斑区,因此,这种疾病对于患者的视力以及生活质量影响显著。针对此类疾病目前主要的治疗方法为玻璃体腔注射抗VEGF药物。
目前各类抗VEGF药物都是单通道的,但眼底疾病为多致病因素性疾病,在临床实践中存在一定的局限性。本次落地的新药物是首个被批准用于眼科的VEGF-A/Ang-2双特异性抗体,在原有抗VEGF治疗的基础上特异性地结合并抑制VEGF-A/Ang-2两种途径,从而稳定血管,比单独抑制任何一种途径更能减少视网膜血管渗漏。
董乐主治医生介绍,根据全球Ⅲ期临床研究结果表明,法瑞西单抗负荷期治疗后可实现75%的患者无积液,80%患者治疗间隔可延长3-4个月。该药物落地我院后,可以为新生血管性(湿性)年龄相关性黄斑变性(nAMD)和糖尿病性黄斑水肿(DME)患者带来新的治疗希望:更好的视力获益,消除视网膜下积液,减少注射频率,减轻患者的经济负担,让患者获得更长期的视力获益和生活质量改善。
2023年12月,该药正式在中国获批上市,自费价格9000元/支。2025年1月1日,《国家基本医疗保险、工伤保险和生育保险药品目录(2024年)》正式落地实施,法瑞西单抗新增进入此版目录,药价降低为3608元/支。陕西省职工医保和居民医保报销比例不同,具体报销金额根据各地医保政策而定。
“感谢医保,一次治疗药费就节省几千元,大大减轻我们老百姓的经济负担。”原叔叔开心地表示。非常庆幸的是原叔叔的治疗效果相当不错,以下是玻璃体腔注药前后病灶区OCT检查的对比。
图为药物注射前

图为药物注射一次后
进入国家医保目录,意味着这一创新药物的可及性将得到进一步改善,在有效缓解眼底病患者经济压力的同时,也能坚定患者接受规范化治疗的信心,标志着眼底疾病治疗迈入重要一步。对于广大眼科患者来说,法瑞西单抗的引进无疑是一个好消息。它不仅为患者提供了新的治疗选择,也为眼科疾病的治愈带来了更多的可能性。西安市第九医院眼科将继续以专业的技术、贴心的服务,守护每一位患者的光明视界。

